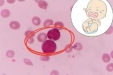
比熊猫血更罕见！新生儿出生24小时，血红蛋白只剩1/3……

新闻动态
-
赋能萌新筑梦医者!我院2026年医学实习生岗前培训圆满结束
 2026-04-02|科教部
2026-04-02|科教部 -
一到阴雨天,关节就“报警”?“关节暖养指南”,比暖宝宝更管用
 2026-04-01|药学部 中医科
2026-04-01|药学部 中医科 -
近日展开四次山地救援!市博爱医院提醒:登山应量力而行,出发前做充分准备
 2026-03-31|中山+
2026-03-31|中山+ -
取了十几个卵,为什么最后只有两三个胚胎?
 2026-03-30|生殖分院
2026-03-30|生殖分院 -
比熊猫血更罕见!新生儿出生24小时,血红蛋白只剩1/3……
2026-03-27|新生儿科
2026-03-27|新生儿科 -
天天喝奶茶,会得糖尿病吗?1分钟自测12个风险因素......
 2026-03-26|内分泌内科
2026-03-26|内分泌内科 -
15分钟内出报告!市博爱医院与国丹中医院建立远程心电联网
 2026-03-24|电生理科
2026-03-24|电生理科 -
检验新星展风采 案例竞技促成长—记“第一届中山市医学检验实习生临床案例竞赛”成功举办
 2026-03-23|检验科
2026-03-23|检验科 -
从肝硬化到癌变仅一步之遥!这8类人立刻自查→
 2026-03-23|消化内科
2026-03-23|消化内科 -
长期睡眠不足的人,后来都怎么样了?答案比你想的更可怕
 2026-03-20|神经内科
2026-03-20|神经内科
